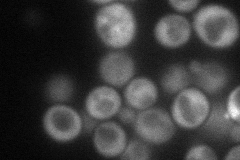
YFL023W
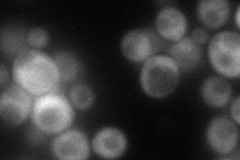
YFL023W
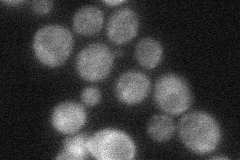
YFL023W
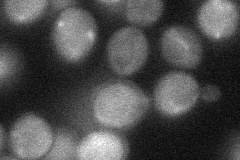
YFL023W
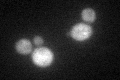
YFL023W

View description
Protein involved in bud-site selection, nutrient signaling, and gene expression controlled by TOR kinase; diploid mutants show a random budding pattern rather than the wild-type bipolar pattern; plays a role in regulating Ty1 transposition
Localization:
Intensity:
Fold change:
Significance:
-
C’ GFP library in SD

cytosol36.31 -
N' NOP1pr-GFP in SD
cytosol65.3335 -
N' TEF2pr-mCherry in SD
cytosol74.7863 -
N' NATIVEpr-GFP in SD
cytosol30.6121 -
N' TEF2pr-VC and Cyto-VN in SD
cytosol36.6849 -
C’ GFP library in SD+DTT
cytosol31.970.88No -
C’ GFP library in SD+H2O2

cytosol33.710.92No -
C’ GFP library in Starvation Media

cytosolN/AN/AYes -
C’ GFP library on the background of Pup2-DaMP

cytosol -
C’ GFP library on the background of CCT mutant

cytosol35.95720.990268No
